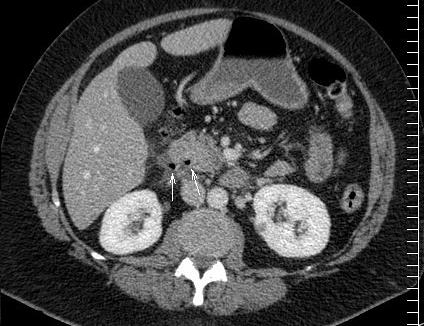

|
Pathologie
radiologique de l'intestin grele :
Technique
radiologique : L'intestin grele
debute au pylore et se termine a la valvule Bauhin . Il se comprendre en deux partie : le duodenum et le jejuno-ileon .
Sa longeur est de 6-7m de long et avait totalement 14,5m2
de surface muqueuse et 56-57m2 si on en comptant des millions
de surface des villocites jejuno-ileales . Les
techniques imageries d'exploration de intestin grele se
basent sur : la radio-standard ASP et de contrast baryte (
enteroclyse ) , echographie -Doppler transcutanee , echo-endoscopie,
la TDM apres remplisage de l'eau ou produit de contrast iode
dilue avec sonde ( entero-scanner ) ou sans sonde et
technique l'entero -IRM :
La radio-standard ASP se realise en position
debout et ce qui peut relevement des signes de perforation
du tube digestif , la occlusion de intestin grele ( image
hydroaerique en niveaux ) et les lesions osseuses de
accompagnement .
Le transit du grele ( opacification baryte ) sans
sonde a ingestion troi fois par 300ml de opaque baryte ., la
progression de la baryte se opacifier la grele de bout en
bout . Ou instillation direct par sonde naso-jejunale (
enteroclyse ) de quelque centaine de ml baryte ou de
contrast hydrosoluble ( en cas avait de signe de perforation
intestinale ) ou bien d'insuffle de air pour
avoir une image en double de contraste . Cette methode peut
raccoucir l'examen et decele de petites stenoses . Les
cliches exposent a suivi la dynamique de la
progression de l'index opaque jusqu'au caecum . La duree de
transit est de 30min a 1 heure
Echographie - Doppler transcutane avec sonde 3,5
et 7,5 ou de plus de MHZ peu apprecie : epaississement
parietale ,la collection des abces , des adenopathies
et des vaisseaux ( artere mesenterique superieure , artere
mesenterique inferieure .)et parfoi permet de guide des
ponctions de biopsies .
La TDM entero-scanner est une nouvelle
methode en combinaison de deux techniques : enteroclyse et
scanner helicoidal . Ce qui peut etre indique de recherche
de tumeur de grele , le bilan des hemorragies digestives ,
occlusion intestinale de bas grade et dans certaine cas de
enterite inflammatoire compliquee
La IRM a enteroclyse peut donne de etude
multiplanaire des tumeur et le bilan d'extension precis des
lesions tumorales
La fibroscopie : methode d'exploratrice restrictive
seul sur la partie superieure du tube digestif arrete au
jejunum et ce qui donne de image macroscopique saint ou
lesionaire de la muqueuse du tube digestif . Biopsie
d'exploratrice peut etre par cette voie .
Images radiologique normale de intestin grele
baryte ( enteroclyse ) , a TDM et a echographie :
Generalement
intestin grele est
un tube musculaire de 6 a 8 m de longeur , a diametre
15/20mm avec des plies muqueuses en forme de valvules
conniventes avec anses relie au mesentere . Jejunum est
proximale et ilion est en distal , il se termine par valvule
ileocaecale et il est vascularisation par artere et veine
mesenterique superieure . Par la technique de opacification
baryte de l'intestin grele ( enteroclse ) , image
radiologique receillir sont : .les plies muqueuses intestinale avient une
epaissisement de 1,5-2mm ,aspect en feuille de fougere au
niveau jejunale , espace inter des plies est
moindre de 5mm et 15mm de ileon . Et a etat normale ,l'espace
inter-anse ne depasse pas 3mm et la largeur d'une anse
intestinale est 25mm
| |
 |
 |
|
| |
Images
radiologiques normales de intestin . Technique est
realise par une sonde
duodenal apres intiller150-200ml de baryte . C'est
un tube musculaire de 6 a 8 m de longeur , a diametre
15/20mm avec des plies muqueuses en forme de valvules
conniventes avec anses relie au mesentere . Jejunum est
proximale et ilion est en distal . Il se termine par valvule
ileocaecale |
 |
Anse de l'intestin :
Espace inter-anse ne depasse pas 3mm et sa
largeur est 25mm |
|
|
| |
 |
Pres de valve Ileo-ceacale , intestin grele
se diminue sa diametre et est moindre des plies
muqueuse que des anses de petit intestin |
|
Image radiologique TDM normale de l'intestin :
| |
|
|
|
| |
 |
|
 |
| |
Il y avait la difference de
image de intestin grele avec gros intestin ( colon )
en coupe TDM axiale . Intestin grele sont en pleine
du contenue , avec plusieure des plies muqueuse . La
colon avait moindre de plie muqueuse et sa diametre est grande et parfois presente
de poche a air . |
|
Images normales
de intestin grele en coupe sagitale .( Click
pour ouvrir agrandissement ) |
Image echographique
normale de l ' intestin :
| |
Intestin grele : Image
echographique normale |
|
|
| |
 |
 |
|
| |
L'epaisseur de la paroi de
l'intestin normalement est en moyen a 3mm avec des
plies muqueuses et de peristaltisme marquee .
Au ileon la hauteur des plies
muquese est diminue et espace entre des plies
muqueuse sont augementes |
Jejunum : Important de
la presence de plissement de la muqueuse et en
connivence |
|
| |
|
|
|
| |
Valvule ileo-coecale :
Image radiologique normale |
|
|
| |
 |
1 - Anse ileale
2 - Valvule
3 - Coecum |
|
| |
|
|
|
Pathologie
radiologique du duodenum .
-
Ulcere duodenal :
Sa incidence est quatre fois de plus que ulcere gastrique
, l'homme est le plus souvent que la femme et na pas de risque
de degenerescence . Image radiologique TOGD un ulcere
duodenal aigue est une niche ronde , ovalaire remplir
de baryte , a entoure par une oedeme peri
lesionelle . Selon a la chronicite , aspect
radiologique des ulceres peuvent se deforme de images en queue de hirondelle ,
a
deux ailes , en chapeau ou en treffle ..
| |
 |
|
 |
|
| |
Aspect un ulcere jeune du
duodenum en TOGD mono contrast baryte avec
compression dosee . Image une niche ovalaire
remplisage par baryte avec etat oedemateuse de la
muqueuse peri lesionaire |
|
Deformation en treffle
un ulcere bulbaire |
|
| |
 |
|
 |
|
| |
Image TOGD mono contrast
baryte un ulcere bulbaire sclerosante avec image de
niche arondie au milieure de la bulbe |
|
Ulcere bulbaire sclerosant
avec deformation en etoile du bulbe . Technique TOGD
a double de contrast |
|
| |
 |
|
 |
|
| |
Deformation en deux
ailes d' ulcere bulbaire avec niche au milieure
.( fleche noire ) |
|
Image TOGD de estoma en decubitus OAD .
Deformation en deux ailes du bulbe . |
|
Les ulcere post bulbaire duodenale est le plus souvent
situe a D1 , D2 au niveau sus-valterien et a bord interne .Endoscopie
a cette portion est difficile . Image TOGD baryte
montre une stenose asymetrique avec image de ulcere au
millieure , aspect de "perle enfilee" .
| |
 |
|
 |
|
| |
Ulcere a bord interieure de
D2 au niveau sus-valerien . Image stenosant de
D2 avec niche remplisage de baryte . |
|
Ulcere stenosant de D2
aspect de " perle filee " avec image d'
epaississement des plies muqueuses duodenum en amont
et au aval ( duodenite ) . |
|
| |
|
|
|
|
Complication de ulcere duodenal est la
stenose , l'obtruction , hemorragie , et la perforation . En
cas de stenose bulbaire et post bulbaire . Image
radiologique TOGD indirect est image de distention
gastrique et de retention du repas au paravent . La TDM en
coupe axiale est tres necessaire pour elimine la stenose
ulceree avec les autres lesions d' extrinseques ou tumorale
. En cas de perforation de ulcere de la face anterieure , la
CT scanner se donne des images de air libre a espace
superieure de l'abdomen et de peritonite . Si la perfotation
situe a la face posterieure de estoma on voyait images
d'epaissisement de la paroi duodenale , lesion inflamatoire
du peritoine au contact et des bulbes d'air justalesionelles
. Sur les hemorragie active du duodenum ,la TDM se
montre encore la fuite d'extravasion vasculaire de
produit de contrast meme au temps plus tardif .
| |
 |
|
 |
|
| |
Complication perfore une
ulcer gastroduodenal est image de croissance gasseuse
sous diapragmatique droit . Cliche de face AP |
|
Sur la TDM en coupe axiale , c'est image
de air libre a espace superieure de l'abdomen .
Ulcere de la face anterieure duodenum perfore |
|
| |
 |
|
|
|
| |
Perforation ulceres duodenale ( face
anterieure ) . Image de air libre a espace
superieure de l'abdomen . |
|
Ulcer de la face posterieure duodenum
perfore . Image de bulbe d'air extravation
exterieure justalesionelle ( fleche blanche )
. Image TDM en coupe axiale . |
|
| |
|
|
|
|
- Duodenite :
il y avait plusieure de sorte duodenite
-Duodenite aigue est tres frequente par infection
de samonella, shigella cholera ou virales ou bien par les
aute cause : alcool , tabac , les corticoides , les AINS ,
mercure , plomb et les laxatif ... Et par ceci il s'agit une
duodenite hemorragique erosive .
- Duodenite chronique non
specifiques est cause au cours des affections
bilio-pancreatique ( cholecystite , angiocholite , lithiase
choledociennes , fistules bilio-duodenale et pancreatite ) '
ou association avec hypertension portale ( 8% ) ou
association avec une gastrite chronique atrophique . Bulbite
et duodenite chronique parfois autonome , ce qui
atteint non seule bulbaire mais en plusieure zone duodenales
, lesion est interstitielle et atrophique . Elles
s'associent volontier a un gastrite antrale (
alcoolique , gros fumeur ) .
- Duodenite chronique
specifique :
Duodenite parasitaire ou fungique , ce qui liee.de
infection par les parasite
: les ankylostomes , strongyloidose , ascaris , schistosoma
, taenia et les amibe . Duodenite
granulomateuse ou maladie de Crohn rare et les
lesions souvent segmentaire en presente les memes caracteres
avec les lesions localise ileale ou colique .Les autres
affections granulomateuses peuvent se presenter au niveau
duodenum : tuberculose , syphilis , sarcoidose, et
histoplasmose . Maladie coeliaque
est une duodenite chronique et auto- immune de intestin liee
a l'ingestion de gluten . Maladie de Whipple . est
maladiee liee a infection de Tropherima whipplei predomine
sur duodeno-jejunum par la presente des gros plies nodulaire
.
-
Duodenite radique :
Est
rare et la lesion apparaitre souvent moins un ans
apres le debut du traitement radiotherapique . Signe de
stenose , ulcere et hemorragique .
Aspects radiologiques des duodenites
aigue sur la TOGD mono de contrast et en double de contrast
apparaisent sur les signes morphologique directement :
| - Des plies muqueuse duodenum plus
de 4mm d'epaisseur |
| - Des nodules muqueux |
| - Des deformations bulbaires |
| - Des erosions duodenales |
Et des signes de trouble fontionnels : hypertonie
et les spasme ou atonie :
 |
 |
 |
| Images de epaissisement en
gros plies de la muqueuse duodenum D2 . Duodenite
bacterienne . |
Meme cas en
double de contrast . L'epaississement de la muqueuse
duodenale est si nette |
Maladie de Whipple :
epaisissement reguliere et legere de plie muquqeuse
de tout la 2e duodenal . Image epaisisement
nodulaire a la region peri-valterienne et
grande empreinte d'origine ganglionaire du
bord interne de D2 |
 |
 |
 |
| Modification des plis
muqueuse duodenum d'origine pancreas : Cancer de la
tete du pancreas . Aspect de retraction en
spiculaire des plis muqueuse gastrique au bord
interne de D2 ( image TOGD en double de contrast ) |
Modification des
plis muqueuse duodenum d'origine pancreatique :
Pancreatite chronique calcifiantes avec aspect
empreine nodulaire du bord interne de D2 . |
Pancreatite aigue pseudo-
tumorale : Image elargissement du cadre
duodenale et elargissement des plies muqueuses
duodenale . |
 |
 |
| Bulbite a relief nodulaire :
Images en nodulaire des plies muqueuse bulbaire et
duodenale . |
Images hypertrophies des
plies muqueuses bulbaire en forme nodulaire |
 |
|
| |
Duodenite atrophique : Aspect duodenum lisse par
atrophie des plies muqueuses du duodenum .. Image
TOGD en double de contrast . |
 |
 |
| Maladie de Crohn duodenale :
Au stade precoce : Aspect flou de bord duodenum par
hypersecretion ( dilution de la baryte ) avec image
micro-ulceration stellaires et aspect reticule de la
muqueuse . Au stade tardif image en stenose duodenum
serre avec image sacculaire du bord interne . |
Duodenite severe grade III .
Image erosion duodenale au niveau du bulbe et image
halo claire , arrondie a reaction oedemateuse des
plies muqueuses duodenales |
Diverticule duodenum : Le duodenum est
la deuxieme location de diverticule apres la colon .
et le plus souvent localise dans la region periampullaire .
Aspect radiologique du diverticule est image de poche
arrondie a paroi mince, limite nette a contemu hydrique ,
gazeuse ou mixte . La perforation est possible spontanee ou
post traumatique . Epanchement gazeuse extra-digestif ,
retroperitoine ou bien fuite extraduodenal de produit de
contrast se presente en cas de perforation de diverticule
. Scanner + ingestion de contrast hydrosoluble est
technique de choix pour diagnostique
 |
|
 |
| Schema de localisation de
diverticule sur la cadre duodenale |
Diverticule de D3 |
Image radiologique TOGD d'une diverticule
de D4 |
 |
 |
| Aspect IRM d'une diverticule
de D2 ( coupe axiale ) |
Diverticule de D2 en coupe TDM axiale
. |
 |
 |
| Deux diverticule du bord
interne de D2 . Image IRM + enteroclyse |
Meme en TDM ( fleche rouge ) |
| |
|
- Maladie
coeliacque: Maladie chronique et auto-imune de
l'intestin par ingestion de gluteine . Atrophie villositaire
se presente souvent sur duodenum -jejunum .Aspect
radiologique est image de duodenite atrophique se voyait
bien sur tOGD ++ double de contrast .et TDM
| |
 |
|
 |
|
| |
Atrophie
de villosite des plies muqueuses duodenale et
jejunum . Image duodenum lisse ( TOGD ++ double de
contrast ). |
|
Atrophie de villosite des plies muqueuse
duodenum-jejunum et propagation etendue de grand
partie de l'intestin . Maladie coeliaque duodenum -
jejunum ( image TDM en coupe coronale ) |
|
| |
 |
|
 |
|
| |
Maladie coeliaque duodeno-jejunum
. Image atrophie et de perdre etendue des villosites
des plies muqueuse duodenale et jejunum . Image TDM
en coupe frontale ( coronale ) . |
|
Image endoscopique duodenum
: atrophie etendue des villosites des plies muqueuse
duodenale . Maladie coeliaque |
|
Polyp
duodenale : Ce sont des adenomes brunnerien
pedicule . Les glandes de Brunner sont des glandes sous
muqueuses du duodenum sus-valterien responsables de la
secretion alcalin bicarbonate . L'hyperplasie reactionelle
de ces glandes se forme en polypoid ou polyp pedicule
. Diagnostique par TOGD monocontrast ou a double de con
trast et fibroscopique . Complication de invagination
duodenoduodenale parfois se presente
| |
 |
|
 |
|
| |
Image TDM en coupe axiale :
Invagination duodenoduodenale par un polyp duodenale
( fleche blannche ) |
|
Meme cas en coupe coronale . |
|
Rupture
duodenale par endoscopie interventionelle :
Rupture de la paroi posterolateral du duodenum presente de
0,3%-1% des cas d'endoscopique . C'est une perforation
retroduodenale qui se traduire par un retropneumoperitoine ,
parfois volumeux et diffuse a distance par voie
sousperitoneal vers la paroi abdominale et le thorax
Page :
1
/
2
/
3
/
4
/
5
/
6
/
7/
8/
9/
<<
PREVIOUS
<<
>> NEXT >>
Gs Bui Binh Tho
|